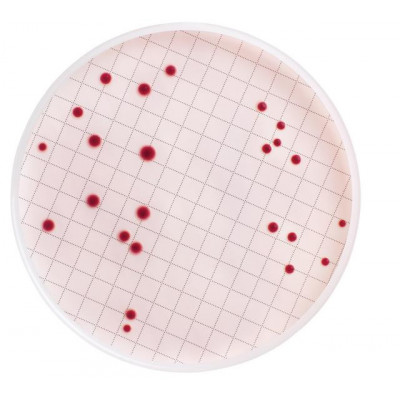
Los Angeles

M ENDO BROTH DESIDRATADO MILLIPORE EMB C/ 100 GR
Modelo: MB000000E
-
R$1.456,66
ou até 3x de R$485,55 sem juros
Economize 5% no PIX: R$1.383,83
ou 3.5% no boleto: R$1.405,68
Descrição
M ENDO BROTH DESIDRATADO FRASCO C/100g MILLIPORE
P/DETERMINACAO DE COLIFORMES TOTAIS
Descrição: meio m-Endo Coliformes Totais (Desidratado)
Dispositivo aplicável: Milliflex e Método MF
Aplicação: Microbiologia de águas
Vinho
Cerveja
Água engarrafada
Cidra
Laboratório clínico
Cosméticos
Análise ambiental
Monitoramento ambiental
Alimentos e bebidas
QC industrial
Filtração para laboratórios
Refrigerantes
Bebidas esportivas
Monitoramento da água
Aparência do organismo: Colônias de coliformes apresentam forte cor vermelha com brilho verde metálico característico
Micro-organismos alvo: Total coliforms
Temperatura de incubação (°C): 35 ± 0,5
Tempo de incubação (h): 24 ± 2
Cor do meio: Dehydrated powder: pinkish purple; prepared medium: pinkish red
Forma do meio: desidratado
pH a 25 °C: 7.2 ± 0.1
Conformidade regulatória: Standard Methods for Examination of Water and WasteWater
Prazo de validade (meses): 60
Embalagem do material: 110 g iem frasco plastico com tampa rosca
P/DETERMINACAO DE COLIFORMES TOTAIS
Descrição: meio m-Endo Coliformes Totais (Desidratado)
Dispositivo aplicável: Milliflex e Método MF
Aplicação: Microbiologia de águas
Vinho
Cerveja
Água engarrafada
Cidra
Laboratório clínico
Cosméticos
Análise ambiental
Monitoramento ambiental
Alimentos e bebidas
QC industrial
Filtração para laboratórios
Refrigerantes
Bebidas esportivas
Monitoramento da água
Aparência do organismo: Colônias de coliformes apresentam forte cor vermelha com brilho verde metálico característico
Micro-organismos alvo: Total coliforms
Temperatura de incubação (°C): 35 ± 0,5
Tempo de incubação (h): 24 ± 2
Cor do meio: Dehydrated powder: pinkish purple; prepared medium: pinkish red
Forma do meio: desidratado
pH a 25 °C: 7.2 ± 0.1
Conformidade regulatória: Standard Methods for Examination of Water and WasteWater
Prazo de validade (meses): 60
Embalagem do material: 110 g iem frasco plastico com tampa rosca